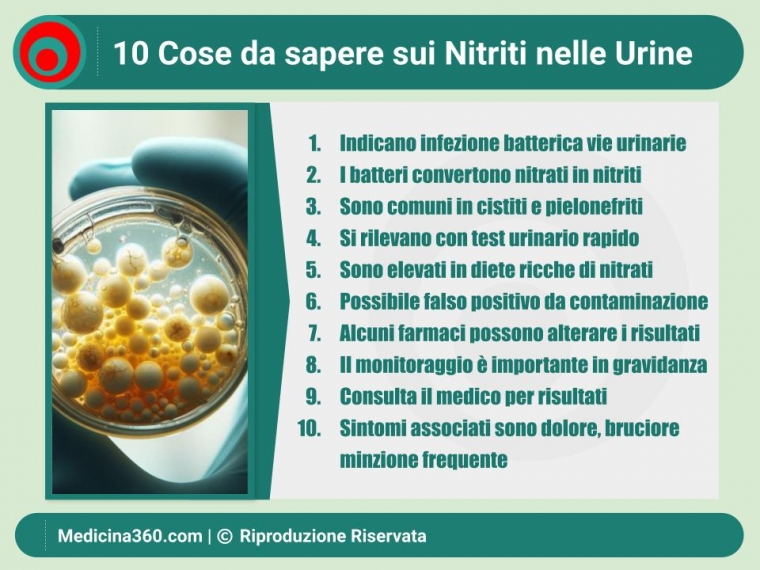
Nitriti nelle Urine: Cosa Significano, Come Rilevarli e Cosa Fare

Nitriti nelle Urine: Cosa Significano, Come Rilevarli e Cosa Fare
Ultimo aggiornamento:
Benvenuto in questo articolo completo sui nitriti nelle urine. Se ti stai chiedendo cosa possano significare i nitriti nel tuo esame delle urine, come vengono rilevati e quali passi dovresti intraprendere, sei nel posto giusto. Copriremo tutto, dagli indicatori di infezioni del tratto urinario (ITU) ai metodi di trattamento e prevenzione, per fornirti una panoramica completa e utile sull'argomento.
Cosa sono i nitriti?
I nitriti sono composti chimici derivati dall'azoto e dall'ossigeno. Essi si formano principalmente attraverso la conversione batterica dei nitrati, presenti in molti alimenti e nell'ambiente circostante.
- Origine dei Nitriti: Spesso, i nitriti provengono dalla conversione dei nitrati, una classe di composti presenti in alimenti come verdure a foglia verde e alcuni tipi di carne.
- Conversione Batterica: I batteri nel nostro organismo, specialmente nel tratto gastrointestinale, sono in grado di convertire i nitrati in nitriti. Questa è una funzione normale e di solito non è motivo di preoccupazione.
- Presenza nelle Urine: Trovare nitriti nelle urine è un fenomeno che ha diverse implicazioni. In molti casi, è un segnale di un'infezione del tratto urinario (ITU), ma non è l'unico motivo possibile.
Importanza di comprendere i nitriti nelle urine
Comprendere il significato dei nitriti nelle urine è fondamentale per una serie di motivi:
- Indicatore di ITU: I nitriti nelle urine sono spesso un segno di infezione del tratto urinario. Queste infezioni variano da lievi a severe e richiedono un intervento medico tempestivo.
- Diagnosi Precoce: Un test delle urine che rivela la presenza di nitriti permette una diagnosi precoce, che a sua volta porta a un trattamento più efficace e meno complicato.
- Esclusione di Altre Cause: Anche se i nitriti sono spesso associati a ITU, possono anche essere presenti per altri motivi. Comprendere questa differenza è cruciale per evitare trattamenti non necessari o inappropriati.
- Salute Generale: Infine, i nitriti nelle urine sono un indicatore del tuo stato di salute generale. Ad esempio, suggeriscono un bilancio alimentare squilibrato o altri problemi metabolici.
- Pianificazione del Trattamento: Una volta identificata la causa, è possibile pianificare un trattamento mirato. Che si tratti di antibiotici per un'ITU o di cambiamenti nella dieta, la comprensione del significato dei nitriti è il primo passo.
Cosa Significano i Nitriti nelle Urine
Hai effettuato un test delle urine e il risultato mostra la presenza di nitriti. Cosa significa esattamente? Nelle righe seguenti, esploreremo il significato clinico dei nitriti nelle urine e perché sono un segnale importante da non ignorare.
Indicatori di infezione del tratto urinario (ITU)
Uno dei motivi più comuni per cui i nitriti appaiono nelle urine è la presenza di un'infezione del tratto urinario, o ITU. Vediamo di capire perché:
- Conversione Batterica: Quando c'è un'infezione, i batteri si moltiplicano nel tratto urinario. Molti di questi batteri convertiranno i nitrati presenti nella dieta o nell'urina in nitriti. Questo processo è un campanello d'allarme per la presenza di un'infezione.
- Tipo di Batteri: Non tutti i batteri convertiranno i nitrati in nitriti. Tuttavia, i colpevoli più comuni, come Escherichia coli (E. coli) e Klebsiella, sono noti per farlo. Quindi, la presenza di nitriti è un indicatore abbastanza specifico.
- Velocità della Diagnosi: Uno dei vantaggi di utilizzare il test dei nitriti come indicatore è che permette una diagnosi più rapida rispetto ad altri metodi come le colture batteriche, che richiedono più tempo.
- Affidabilità del Test: È importante notare che mentre la presenza di nitriti è un segnale forte di ITU, l'assenza di nitriti non esclude completamente la possibilità di un'infezione. Altri test sono necessari per una diagnosi completa.
- Sintomatologia: Spesso, la presenza di nitriti nelle urine è accompagnata da sintomi come bruciore durante la minzione, urgenza frequente o dolore addominale. Se noti questi sintomi, è prudente consultare un medico per ulteriori indagini.
- Esami Supplementari: A seconda dei risultati, il tuo medico potrebbe raccomandare ulteriori esami, come un'ecografia del tratto urinario o test di sensibilità agli antibiotici, per determinare il trattamento più efficace.
Altri fattori che influenzano i livelli di nitriti
Mentre la presenza di nitriti nelle urine è spesso associata a un'infezione del tratto urinario, è importante sottolineare che anche altri fattori influenzano i livelli di nitriti. Di seguito esamineremo alcune di queste cause alternative.
- Allergie e Intolleranze: Sebbene meno comune, alcune allergie o intolleranze alimentari alterano la composizione delle urine, inclusa la presenza di nitriti. Ad esempio, intolleranze a determinati alimenti che contengono nitrati potrebbero portare a livelli elevati di nitriti nelle urine.
- Infezioni Non-Batteriche: Mentre le ITU sono di solito causate da batteri, altre infezioni come quelle fungine (Candida, ad esempio) o virali talvolta alterano i livelli di nitriti, sebbene in modo meno specifico.
- Batteri Non-Patogeni: Non tutti i batteri presenti nel tratto urinario sono dannosi. Alcuni batteri non-patogeni servono anche alla conversione di nitrati in nitriti, portando a un risultato positivo senza segnali di infezione.
- Presenza di Funghi: In casi rari, infezioni fungine del tratto urinario portano a un aumento dei nitriti. Questo è più comune in individui con un sistema immunitario compromesso.
- Infezioni Virali: Anche se è raro, alcune infezioni virali influenzano indirettamente i livelli di nitriti. Questo accade quando il virus altera l'equilibrio del microbioma, permettendo ai batteri di convertire i nitrati in nitriti.
- Stato di Salute Generale: Fattori come stress, disidratazione e squilibri ormonali influenzano la composizione delle urine, inclusi i livelli di nitriti.
- Farmaci e Trattamenti: Alcuni farmaci, in particolare quelli che influenzano il bilancio idrico o l'equilibrio acido-base, alterano i livelli di nitriti nelle urine.
- Dieta e Alimentazione: Un'alimentazione ricca di nitrati, come quella che include molte verdure a foglia verde, naturalmente porta livelli elevati di nitriti nelle urine.
Come Vengono Rilevati i Nitriti nelle Urine
Capire come i nitriti nelle urine vengono rilevati è un passo fondamentale per interpretare i risultati degli esami delle urine e per valutare la vostra condizione di salute. Ecco una panoramica completa su come avviene questa identificazione.
Valori dei Nitriti nelle Urine
Quando si tratta di nitriti, i termini come "positivo" o "negativo" sono più comunemente usati rispetto a "alti" o "bassi". Vediamo di capire meglio cosa significano questi valori.
- Valori Normali: In generale, l'assenza di nitriti ("negativo") nelle urine è considerata normale e indica che probabilmente non c'è un'infezione del tratto urinario in corso.
- Valori Alti (Positivo): Un risultato "positivo" per i nitriti nelle urine è un segnale forte che potrebbe esserci un'infezione batterica del tratto urinario. In questo caso, ulteriori test e trattamento sono necessari.
- Valori Bassi (Negativo ma con Sintomi): Se il test è negativo ma ci sono sintomi come dolore alla minzione, potrebbe essere necessario un ulteriore esame. Alcuni batteri non convertono i nitrati in nitriti, rendendo il test non completamente affidabile in tutti i casi.
- Falsi Positivi/Negativi: Come con qualsiasi test diagnostico, ci sono sempre eccezioni e possibilità di falsi positivi o falsi negativi. Ad esempio, alcuni alimenti o farmaci influenzano i risultati del test.
- Interpreting Results in Conjunction with Other Tests: Un test per i nitriti non è l'unico indicatore di un problema. Spesso viene utilizzato in combinazione con altri test come l'urinocoltura o l'esame microscopico delle urine per un'analisi più completa.
Test di Striscia Reattiva (Test a Casa)
Esaminiamo ora una delle tecniche più accessibili e convenienti per il monitoraggio dei nitriti nelle urine: il test di striscia reattiva. Questo test è spesso utilizzato per un controllo rapido e viene effettuato direttamente a casa.
- Facilità d'Uso: Una delle principali attrattive di questo test è la sua semplicità. Basta immergere la striscia nell'urina e attendere alcuni minuti per il risultato.
- Indicazioni: Un cambiamento di colore sulla striscia suggerisce la presenza di nitriti, che potrebbe indicare un'infezione del tratto urinario (ITU).
- Limiti: Questi test possono dare falsi positivi e negativi. Ad esempio, l'assunzione di alcuni alimenti influenza il risultato.
- Costo-Efficienti: Sono un'opzione più economica rispetto ai test di laboratorio, ma non dovrebbero sostituire un'analisi più approfondita se si sospetta un problema serio.
Analisi Colturale delle Urine
Se i test rapidi a striscia indicano la presenza di nitriti, il passo successivo è spesso un'analisi colturale delle urine per una diagnosi più precisa.
- Procedure: In laboratorio, un campione di urina è seminato su un terreno di coltura. Se i batteri crescono, viene esaminato il tipo e il numero per determinare la gravità dell'infezione.
- Sensibilità e Specificità: L'analisi colturale è uno strumento molto più preciso e affidabile per identificare il tipo di batteri presenti, rendendola cruciale per la scelta del trattamento antibiotico appropriato.
- Tempo di Attesa: A differenza del test rapido, i risultati richiedono qualche giorno per essere disponibili.
- Costi e Disponibilità: Questo test è generalmente più costoso e richiede l'intervento di professionisti del settore sanitario per la raccolta del campione e l'interpretazione dei risultati.
- Quadro Completo: L'analisi colturale delle urine è spesso eseguita in congiunzione con altri test e esami per offrire un quadro clinico completo.
Consultare un medico per interpretare correttamente i risultati di qualsiasi test urinario e per decidere il miglior corso d'azione terapeutica per voi.
Tecniche Avanzate
Oltre ai metodi più comuni come il test di striscia reattiva e l'analisi colturale, esistono anche tecniche più avanzate per l'individuazione dei nitriti nelle urine. Queste sono generalmente utilizzate in contesti di ricerca o per casi più complessi che richiedono un'indagine più dettagliata.
Cromatografia a Gas-Spettrometria di Massa (GC-MS)
- Caratteristiche: Questa tecnica è in grado di analizzare composti organici volatili, offrendo un quadro dettagliato delle sostanze presenti nell'urina.
- Applicazioni: Utilizzata principalmente nella ricerca scientifica e nei casi clinici complessi.
- Precisione: Fornisce dati molto precisi ma è costosa e richiede apparecchiature specializzate.
Spettroscopia NMR (Risonanza Magnetica Nucleare)
- Dettaglio: Questa tecnica utilizza il magnetismo per analizzare la struttura molecolare delle sostanze.
- Vantaggi: Rivela la presenza di nitriti e altri composti con alta precisione.
- Limitazioni: Come la GC-MS, è costosa e richiede un'alta specializzazione.
Analisi Multiparametrica
- Completo: Questo test analizza diversi parametri in un unico esame, fornendo un quadro clinico più completo.
- Interpretazione: La complessità dei dati raccolti rende necessaria l'intervento di specialisti per interpretare i risultati.
- Costi: Generalmente più costoso dei metodi standard, ma è utile in situazioni che richiedono un'analisi più approfondita.
Test Molecolari (PCR)
- Sensibilità: Questi test sono estremamente sensibili e identificano specifici tipi di batteri o virus.
- Rapidezza: A differenza dell'analisi colturale, i risultati sono disponibili più rapidamente.
- Applicazioni: Utili in situazioni in cui si necessita di un'identificazione rapida e accurata del patogeno responsabile.
Ognuna di queste tecniche avanzate ha i suoi punti di forza e di debolezza, e la scelta del metodo più adatto dipenderà dai dettagli clinici del caso e dalle risorse disponibili. Importante è sempre consultare un medico specializzato per una diagnosi accurata e un trattamento mirato.
In ogni caso queste tecniche avanzate non sostituiscono i metodi standard, ma forniscono ulteriori informazioni preziose per una diagnosi più accurata e un trattamento più efficace.
Sintomi Associati a Livelli Elevati di Nitriti
Ora che abbiamo discusso dei vari modi per identificare la presenza di nitriti nelle urine, è altrettanto importante comprendere quali sintomi potrebbero essere associati a livelli elevati di questi composti. Spesso, la presenza di nitriti è un segno di un'infezione del tratto urinario (ITU), ma è essenziale non trascurare altri sintomi che potrebbero suggerire problemi diversi o più gravi.
Sintomi comuni di ITU
Un'infezione del tratto urinario è una delle cause più frequenti di alti livelli di nitriti nelle urine. I sintomi di un ITU variano in gravità e comprendono:
Disuria (Bruciore o Dolore durante la Minzione)
- Descrizione: La disuria è uno dei sintomi più comuni e fastidiosi.
- Attenzione: Se avvertite bruciore persistente, consultate immediatamente un medico.
Aumento della Frequenza Urinaria
- Dettagli: Sentire il bisogno di urinare più spesso del normale.
- Cosa fare: Un aumento improvviso della frequenza urinaria dovrebbe essere valutato da un professionista della salute.
Urina Torbida o Maleodorante
- Indicatori: Un aspetto torbido o un cambiamento nell'odore dell'urina è un segno di infezione.
- Precauzioni: Non trascurate questi sintomi, soprattutto se persistono.
Dolore nella Parte Inferiore dell'Addome
- Sintomi: Può essere lieve o acuto e spesso è associato a un disagio durante la minzione.
- Azioni: Qualsiasi dolore addominale persistente dovrebbe essere esaminato da un medico.
Febbre e Brividi
- Importanza: La presenza di febbre indica spesso che l'infezione è più grave e potrebbe aver raggiunto i reni.
- Consiglio: La febbre, soprattutto se accompagnata da altri sintomi, necessita di un intervento medico rapido.
Sangue nell'Urina
- Gravità: il sangue nelle urine è un sintomo grave che richiede attenzione medica immediata.
- Note: Il sangue si presenta come un colore rosa, rosso o marrone nell'urina.
La presenza di uno o più di questi sintomi richiede una valutazione medica per confermare o escludere la presenza di un ITU. È sempre meglio consultare un medico per una diagnosi accurata e per discutere delle opzioni di trattamento più appropriate per il vostro caso specifico.
Sintomi meno comuni
Oltre ai sintomi frequentemente associati a un’infezione del tratto urinario e alti livelli di nitriti, esistono sintomi meno comuni che sono segnali di allarme. Questi sintomi non devono essere trascurati e potrebbero indicare una situazione clinica più complessa o diversa.
Affaticamento e Debolezza Generale
- Descrizione: Una sensazione di stanchezza persistente che non si allevia con il riposo.
- Attenzione: L'affaticamento è il sintomo di diverse condizioni mediche e dovrebbe essere valutato.
Confusione o Cambiamenti Mentali
- Dettagli: Particolarmente comuni negli anziani, questi sintomi indicano un’infezione più severa.
- Raccomandazioni: Consultare un medico se si notano cambiamenti cognitivi inspiegabili.
Dolore alla Schiena o ai Fianchi
- Note: Questo indica che l'infezione si è diffusa ai reni.
- Consiglio: Un dolore persistente nella zona lombare richiede una visita medica.
Nausea e Vomito
- Descrizione: Anche se rari, questi sintomi si manifestano in casi più gravi.
- Precauzioni: Nausea e vomito in combinazione con altri sintomi necessitano di attenzione medica immediata.
Ritenzione Urinaria
- Indicatori: Difficoltà a urinare nonostante l'urgenza o il bisogno frequente.
- Cosa fare: Questo è un sintomo serio che richiede un esame medico rapido.
Febbre Alta
- Importanza: Una febbre molto alta potrebbe essere un segno di un’infezione più grave o complicata.
- Azioni consigliate: Ogni febbre alta dovrebbe essere trattata come un'emergenza medica.
Gonfiore Addominale
- Dettagli: Raramente, un’infezione del tratto urinario causa gonfiore addominale.
- Passi da seguire: Consultare un medico se si verifica un gonfiore inspiegabile.
Trattamento e Gestione
Dopo aver identificato la presenza di nitriti nelle urine e aver valutato i sintomi associati, il passo successivo è il trattamento e la gestione della condizione sottostante. Non tutte le situazioni richiedono un trattamento aggressivo, ma la diagnosi precoce è fondamentale per determinare il miglior percorso terapeutico.
Antibiotici comuni
Quando i nitriti nelle urine sono collegati a un'infezione del tratto urinario (ITU), gli antibiotici rappresentano il pilastro del trattamento. Di seguito sono elencati alcuni degli antibiotici comunemente prescritti per affrontare questo tipo di infezione.
Trimetoprim/Sulfametossazolo (Bactrim, Septra)
- Utilizzo: Uno degli antibiotici più frequentemente utilizzati per le ITU.
- Note di cautela: Causa effetti collaterali come nausea e eruzioni cutanee.
Nitrofurantoina (Macrobid)
- Descrizione: Efficace contro un ampio spettro di batteri.
- Riserve: Meno adatta se l'infezione si è diffusa ai reni.
Ciprofloxacina (Cipro)
- Caratteristiche: Un antibiotico fluorochinolonico potente.
- Precauzioni: Riserva d'uso per infezioni più gravi a causa del potenziale di effetti collaterali gravi.
Fosfomicina (Monuril)
- Dettagli: Utilizzato per trattamenti singoli e brevi.
- Vantaggi: Molto utile per chi ha problemi di tolleranza ad altri antibiotici.
Amoxicillina e Acido clavulanico (Augmentin)
- Uso comune: Spesso utilizzato per una varietà di infezioni batteriche.
- Attenzione: interagisce con alcuni farmaci e causa effetti collaterali gastrointestinali.
Considerazioni sui Farmaci
- Resistenza agli antibiotici: L'uso improprio di antibiotici porta alla resistenza. Sempre completare il ciclo di trattamento prescritto.
- Interazioni farmacologiche: Alcuni antibiotici interagiscono con altri farmaci. Discutere con il medico tutte le medicine che si stanno assumendo.
- Controindicazioni e Allergie: Informare il medico di eventuali allergie o altre condizioni mediche che potrebbero interferire con il trattamento antibiotico.
Rimedi naturali
Oltre agli antibiotici, esistono alcune opzioni di trattamento più naturali . È fondamentale consultare il medico prima di intraprendere qualsiasi approccio alternativo.
Nitriti nelle urine e Dieta
- Mirtilli: Sono noti per le loro proprietà antibatteriche e sono utili nella prevenzione delle ITU.
- Acqua: L'incremento del consumo di acqua aiuta a diluire le urine e a eliminare i batteri.
- Probiotici: Alimenti come lo yogurt contengono batteri buoni che aiutano a bilanciare la flora intestinale e urinaria.
- Evitare cibi irritanti: Alimenti ad alto contenuto di acidi e spezie aggravano i sintomi di un'ITU.
Esercizio fisico e Nitriti nelle Urine
- Esercizi pelvici: Rinforzano i muscoli del pavimento pelvico e riducono il rischio di ITU ricorrenti.
- Evitare il sovrappeso: Un peso corporeo equilibrato riduce la pressione sulla vescica e minimizza il rischio di infezioni.
Gruppi a Rischio e Fattori di Rischio
Alcune popolazioni sono più a rischio di sviluppare alti livelli di nitriti nelle urine a causa di vari fattori come età, stato di salute e condizioni specifiche come la gravidanza.
Donne in Gravidanza
La gravidanza è un periodo in cui il corpo subisce numerose modifiche, compreso il sistema urinario. Questo rende le donne in gravidanza particolarmente suscettibili a infezioni del tratto urinario (ITU) e, di conseguenza, a livelli elevati di nitriti nelle urine.
- Gravidanza Precoce: Nelle prime fasi della gravidanza, i cambiamenti ormonali portano un rilassamento delle vie urinarie, facilitando l'ingresso di batteri. È fondamentale effettuare controlli medici regolari.
- Gravidanza Avanzata: A mano a mano che la gravidanza progredisce, l'utero ingrandito esercita pressione sulla vescica, ostacolando un completo svuotamento e favorendo le infezioni.
- Gravidanza Gemellare e Tripla: In gravidanze multiple, la pressione sulla vescica e sul tratto urinario è ulteriormente incrementata, aumentando il rischio di ITU e nitriti nelle urine.
- Bambini Prematuri: Un'elevata presenza di nitriti nelle urine della madre è un indicatore di rischio per la nascita prematura.
- Bambini Malati: Se la madre ha avuto livelli elevati di nitriti durante la gravidanza, c'è un aumento del rischio che il neonato possa sviluppare problemi correlati, come infezioni.
Consigli per le Donne in Gravidanza
- Controlli Medici: È vitale per le donne in gravidanza sottoporsi a controlli medici regolari e esami delle urine per monitorare i livelli di nitriti.
- Idratazione: Bere abbondante acqua aiuta a prevenire le ITU.
- Igiene: Mantenere un'igiene personale accurata riduce significativamente il rischio di infezioni.
Nota: È sempre consigliabile consultare un medico per una diagnosi accurata e un piano di trattamento personalizzato, soprattutto se si rientra in uno dei gruppi a rischio.
Nitriti nelle Urine nelle Donne
Oltre alla gravidanza, esistono altri scenari specifici che rendono le donne più vulnerabili a infezioni del tratto urinario e, quindi, a una potenziale presenza di nitriti nelle urine.
- Donna in Menopausa: La diminuzione degli estrogeni durante la menopausa rende il tratto urinario meno resistente alle infezioni. Questo porta a un aumento dei nitriti nelle urine.
- Donna con Incontinenza: L'incontinenza urinaria causa residui di urina nella vescica, creando un ambiente favorevole alla crescita batterica.
- Donna con Cistite: Questa infiammazione della vescica è spesso associata a un aumento di nitriti nelle urine, poiché è generalmente causata da un'infezione batterica.
- Donna con Infezioni Urinarie Ricorrenti: In questi casi, i livelli elevati di nitriti potrebbero essere un segnale di allarme di un problema persistente che richiede attenzione medica.
Consigli per le Donne
- Controlli regolari: Sottoporsi a test urinari frequenti per monitorare i nitriti è molto utile.
- Alimentazione e idratazione: Una dieta equilibrata e un buon livello di idratazione contribuiscono a mantenere un tratto urinario sano.
- Consultazione medica: In presenza di sintomi o fattori di rischio, è imperativo consultare un medico per una diagnosi accurata e un piano di trattamento.
Nitriti nelle Urine negli Uomini
Gli uomini non sono immuni alla presenza di nitriti nelle urine, soprattutto in determinate circostanze.
- Uomo con Prostata Ingrossata: Un ingrossamento della prostata ostacola il flusso di urina, aumentando il rischio di infezioni e, di conseguenza, i livelli di nitriti.
- Uomo con Incontinenza: Come per le donne, l'incontinenza crea un ambiente favorevole alla crescita di batteri nella vescica.
- Uomo con Cistite: Sebbene meno comune negli uomini, la cistite è anch'essa una causa di elevati livelli di nitriti nelle urine.
Consigli per gli Uomini
- Screening Prostatico: Gli uomini con prostata ingrossata dovrebbero sottoporsi a controlli medici regolari.
- Igiene e Stile di Vita: Mantenere uno stile di vita sano e una buona igiene personale riduce il rischio di infezioni.
- Consultazione medica: In caso di sintomi, è fondamentale consultare un medico per una valutazione completa.
Anziani
L'invecchiamento porta con sé diversi cambiamenti fisiologici che rendono le persone anziane più suscettibili a varie condizioni mediche, comprese le infezioni del tratto urinario (ITU).
- Sistema Immunitario Compromesso: Con l'avanzare dell'età, il sistema immunitario diventa meno efficace, rendendo gli anziani più vulnerabili a infezioni e conseguentemente a un aumento dei nitriti nelle urine.
- Mobilità Ridotta: Spesso, la mobilità ridotta porta a una minore assunzione di liquidi, creando un ambiente favorevole alla crescita batterica nel tratto urinario.
- Medicazioni Prolungate: L'uso di cateteri o altri dispositivi medici aumenta il rischio di infezioni urinarie.
Consigli per gli Anziani
- Idratazione: È fondamentale mantenere un adeguato apporto di liquidi.
- Monitoraggio Medico: Controlli medici regolari e test delle urine servono a prevenire complicazioni.
- Igiene Personale: Mantenere una buona igiene personale è cruciale per ridurre il rischio di ITU.
Persone con Malattie Croniche
Le persone con condizioni mediche croniche sono a maggior rischio di sviluppare alti livelli di nitriti nelle urine per diverse ragioni.
- Diabete: Questa malattia compromette il sistema immunitario e porta a frequenti infezioni urinarie.
- Malattie Renali Croniche: Un funzionamento renale compromesso porta a un aumento del rischio di infezioni del tratto urinario.
- Immunosoppressione: Le persone con malattie che sopprimono il sistema immunitario sono più a rischio.
Consigli per Chi ha Malattie Croniche
- Monitoraggio Regolare: È fondamentale eseguire controlli medici e test delle urine regolari.
- Consultazione Medica: Avere una strategia di trattamento personalizzata con il proprio medico è essenziale.
- Stile di Vita Sano: Alimentazione equilibrata e attività fisica moderata contribuiscono al benessere generale e ridurre il rischio di infezioni.
Nitriti nelle Urine nei Bambini
I bambini, specialmente nei primi anni di vita, sono particolarmente vulnerabili a infezioni del tratto urinario (ITU) e, di conseguenza, alla presenza di nitriti nelle urine. Ecco alcuni aspetti da considerare:
- Sistema Immunitario in Sviluppo: I bambini hanno un sistema immunitario ancora in fase di maturazione, il che li rende più suscettibili a varie infezioni.
- Idratazione Inadeguata: I bambini, specialmente quelli più piccoli, non bono abbastanza liquidi, il che contribuisce a infezioni urinarie.
- Segnalazione dei Sintomi: I bambini più piccoli potrebbero non essere in grado di comunicare chiaramente i sintomi, rendendo difficile la diagnosi tempestiva di un'ITU.
- Pannolini: L'uso di pannolini crea un ambiente umido che favorisce la proliferazione batterica.
- Struttura Anatomica: A volte, difetti anatomici congeniti del tratto urinario aumentano il rischio di ITU.
Consigli per i Genitori
- Monitoraggio Attento: Osservate eventuali segni di disagio nel vostro bambino, come pianto durante la minzione o febbre senza motivo apparente.
- Idratazione: Assicuratevi che il bambino beva liquidi in modo regolare.
- Visite Pediatriche Regolari: Sottoporre il bambino a controlli regolari aiuta nella diagnosi precoce di eventuali problemi.
- Igiene: Mantenere un'adeguata igiene personale è essenziale per prevenire infezioni.
Prevenzione
La prevenzione è sempre meglio che curare, specialmente quando si tratta di infezioni del tratto urinario o di altri problemi che causano alti livelli di nitriti nelle urine.
- Igiene personale: Mantenere un'adeguata igiene intima è cruciale. Utilizzare sapone neutro e acqua per pulire la zona genitale.
- Vuotare la vescica regolarmente: Non trattenere l'urina per periodi prolungati, in quanto ciò può favorire la crescita batterica.
- Usare protezioni durante i rapporti sessuali: L'utilizzo del preservativo riduce il rischio di ITU e, di conseguenza, i livelli di nitriti nelle urine.
- Evitare l'uso eccessivo di antibiotici: Come già menzionato, l'abuso di antibiotici porta a resistenza, rendendo più difficile il trattamento delle future infezioni.
- Alimentazione equilibrata e stile di vita sano: Mantenere una dieta bilanciata ricca di frutta e verdura e fare esercizio regolare può rinforzare il sistema immunitario e ridurre il rischio di infezioni.
Mantenere uno stile di vita sano, fare scelte alimentari intelligenti e adottare buone pratiche di igiene può fare una grande differenza nella prevenzione delle infezioni del tratto urinario e nella gestione dei livelli di nitriti nelle urine.
Nota: È sempre consigliabile consultare un medico per una diagnosi accurata e un piano di trattamento personalizzato, soprattutto se si hanno sintomi persistenti o gravi.
Domande Frequenti
Ecco alcune domande frequenti che aiutano a chiarire dubbi e incertezze.
I nitriti nelle urine sono sempre un segno di ITU?
No, la presenza di nitriti nelle urine non è un segnale definitivo di un'infezione del tratto urinario (ITU). Benché sia un indicatore comune, ci sono altre cause. Allo stesso modo, non tutte le ITU producono nitriti nelle urine.
Posso avere un ITU anche se il test dei nitriti è negativo?
Assolutamente sì. Un test negativo per i nitriti non esclude la possibilità di un'ITU. Alcuni batteri che causano ITU non convertano i nitrati in nitriti. Perciò, potrebbe essere necessario condurre ulteriori esami per una diagnosi accurata.
I nitriti nelle urine possono essere causati da alimenti o farmaci?
Mentre alimenti ricchi di nitrati come spinaci o barbabietole influenzano i livelli di nitrati, non hanno un impatto diretto sui nitriti nelle urine. Tuttavia, alcuni farmaci e condizioni mediche interferiscono con i test dei nitriti, dando risultati falsi-positivi o falsi-negativi.
Quali sono le complicazioni dei nitriti nelle urine?
Le complicazioni variano in base alla causa sottostante. Se i nitriti sono indicativi di un'ITU non trattata, le possibili complicanze includono:
- Pielonefrite (infezione renale)
- Setticemia (infezione del sangue)
- Problemi di minzione a lungo termine
I nitriti nelle urine sono sempre indicativi di un'infezione urinaria?
No, i nitriti nelle urine non sono sempre un segno inconfondibile di un'infezione urinaria (IU). Benché spesso si trovino in contesti di IU, la loro presenza è anche dovuta ad altri fattori. Pertanto, è importante consultare un medico per una diagnosi completa.
I nitriti nelle urine possono essere presenti anche in assenza di infezione urinaria?
Sì, è possibile. I nitriti appiono nelle urine anche a causa di altri fattori, come ad esempio la contaminazione del campione urinario o in rari casi, alcune condizioni metaboliche.
I nitriti nelle urine possono essere causati da un'alimentazione ricca di nitrati?
Gli alimenti ricchi di nitrati, come alcune verdure a foglia verde, non causano necessariamente un aumento dei nitriti nelle urine. Tuttavia, aumentano i livelli di nitrati, che sono diversi dai nitriti e non sono di per sé un indicatore di infezione urinaria.
I nitriti nelle urine possono essere causati da un uso eccessivo di antibiotici?
Un uso eccessivo di antibiotici porta a una resa di batteri resistenti, che potrebbero non convertire i nitrati in nitriti. In questo caso, un test per i nitriti potrebbe risultare negativo anche in presenza di una IU. È importante non autodiagnosticarsi e seguire le indicazioni mediche per l'uso degli antibiotici.
I nitriti nelle urine possono essere causati da una prostatite?
In caso di prostatite batterica, è possibile che si verifichi una presenza di nitriti nelle urine. Questa condizione si riferisce all'infiammazione della prostata, spesso causata da un'infezione batterica. I batteri coinvolti convertono i nitrati a nitriti, rendendo un test urinario positivo per i nitriti.
I nitriti nelle urine possono essere causati da una cistite?
Assolutamente sì. La cistite è una delle cause più comuni di presenza di nitriti nelle urine. Trattandosi di un'infezione della vescica, spesso da batteri che provengono dal tratto intestinale, i test urinari frequentemente mostrano un risultato positivo per i nitriti.
I nitriti nelle urine possono essere causati da un'uretrite?
Anche in questo caso, la risposta è affermativa. L'uretrite, o infiammazione dell'uretra di origine batterica, porta, alla presenza di nitriti nel test urinario.
I nitriti nelle urine possono essere causati da una pielonefrite?
La pielonefrite è un'infezione renale spesso causata da batteri che si sono mossi verso l'alto dal tratto urinario inferiore. Anche in questo caso, è possibile che i nitriti siano presenti nelle urine come segno di infezione.
I nitriti nelle urine possono essere causati da una nefrite interstiziale?
La nefrite interstiziale è più comunemente una malattia infiammatoria del rene che non è tipicamente causata da batteri. Pertanto, è meno probabile che questa condizione porti alla presenza di nitriti nelle urine.
I nitriti nelle urine possono essere causati da una malattia renale cronica?
La malattia renale cronica (MRC) generalmente non causa direttamente la presenza di nitriti nelle urine. Tuttavia, le persone con MRC sono più suscettibili alle infezioni del tratto urinario (ITU), che portano a un test positivo per i nitriti.
I nitriti nelle urine possono essere causati da una gravidanza?
La gravidanza non causa direttamente la presenza di nitriti nelle urine. Però, durante la gravidanza, le variazioni ormonali e fisiche rendono le donne più suscettibili alle ITU. Un test urinario potrebbe quindi rivelare nitriti se vi è un'infezione urinaria.
I nitriti nelle urine possono essere causati da una menopausa?
Come nella gravidanza, anche la menopausa non è direttamente collegata ai nitriti nelle urine. Ma la diminuzione degli estrogeni e le modifiche nella flora microbica predispongono a infezioni urinarie, risultando in un test positivo per i nitriti.
I nitriti nelle urine possono essere causati da una malattia infiammatoria pelvica (MIP)?
La Malattia Infiammatoria Pelvica (MIP) è principalmente un'infezione dei genitali femminili superiori, che spesso è causata da batteri. Tuttavia, questa condizione non porta tipicamente alla presenza di nitriti nelle urine, a meno che non vi sia un'infezione urinaria concomitante.
I nitriti nelle urine possono essere causati da una malattia autoimmune?
Le malattie autoimmuni come il lupus eritematoso sistemico danneggiano i reni e predisporre a ITU, ma generalmente non causano direttamente un test positivo per i nitriti nelle urine. Qualsiasi presenza di nitriti dovrebbe essere ulteriormente indagata per escludere altri fattori, come le infezioni urinarie.
I nitriti nelle urine possono essere causati da un tumore del tratto urinario?
Un tumore del tratto urinario, come un tumore alla vescica o ai reni, generalmente non è direttamente responsabile della presenza di nitriti nelle urine. Tuttavia, un tumore crea un ambiente favorevole alla proliferazione batterica, portando indirettamente a infezioni del tratto urinario (ITU) che generano un test positivo per i nitriti.
I nitriti nelle urine possono essere causati da un disturbo neurologico?
I disturbi neurologici come la sclerosi multipla o il morbo di Parkinson compromettono la funzione vescicale, portando a ristagni di urina e quindi a un aumento del rischio di ITU. Ma di per sé, queste condizioni non causano la presenza di nitriti nelle urine.
I nitriti nelle urine possono essere causati da un disturbo metabolico?
I disturbi metabolici come il diabete predispongono a ITU a causa di un sistema immunitario compromesso e alte concentrazioni di zucchero nelle urine. Pertanto, mentre la condizione stessa non genera nitriti, porta a un ambiente che favorisce la crescita batterica e la conversione di nitrati a nitriti.
I nitriti nelle urine possono essere causati da un disturbo ormonale?
Disturbi ormonali come l'ipotiroidismo o il Cushing hanno un impatto sul sistema immunitario e sul metabolismo, ma generalmente non sono direttamente correlati alla presenza di nitriti nelle urine. Ancora una volta, un test positivo per nitriti è più spesso un segno di una ITU sottostante.
I nitriti nelle urine possono essere causati da un disturbo funzionale?
I disturbi funzionali del tratto urinario come la vescica iperattiva o il reflusso vescico-ureterale causano ristagni di urina, che a loro volta portano a ITU e quindi a nitriti nelle urine. Ma questi disturbi in sé non causano la presenza di nitriti.
Approfondimenti
Nitriti nelle Urine: Biomarcatori di Infezione e Tecnologie Avanzate per la Rilevazione
I nitriti nelle urine rappresentano uno degli indicatori più significativi nelle diagnosi di infezioni del tratto urinario (UTI). La loro presenza è considerata un segnale diretto dell'attività batterica, in quanto i batteri, particolarmente quelli patogeni come l'Escherichia coli, convertono i nitrati presenti naturalmente nelle urine in nitriti. La rilevazione di nitriti, quindi, suggerisce una infezione batterica attiva nel sistema urinario.
La diagnosi precoce e accurata delle UTI è fondamentale per prevenire complicanze gravi, come la pielonefrite o la sepsi, specialmente in popolazioni ad alto rischio come donne incinte, bambini, e pazienti immunocompromessi o con cateteri urinari permanenti. La valutazione dei nitriti nelle urine, come illustrato da Gupta et al. (2017) e Schmiemann et al. (2015), offre un metodo rapido e non invasivo per l'identificazione di infezioni, supportando decisioni cliniche tempestive e appropriate.
Avanzamenti Tecnologici nella Rilevazione dei Nitriti
Le tecniche di rilevazione dei nitriti hanno visto significativi avanzamenti negli ultimi anni. Tradizionalmente, il test si effettuava mediante strisce reattive immerse in un campione di urina, con un cambio di colore che indicava la presenza di nitriti. Tuttavia, recenti innovazioni tecnologiche hanno migliorato l'accuratezza, la sensibilità e la specificità di questi test. Tecnologie basate su sensori elettrochimici, ad esempio, offrono risultati più precisi in tempi brevi, permettendo una diagnosi rapida e un trattamento tempestivo delle UTI.
Inoltre, lo sviluppo di piattaforme digitali per l'analisi delle urine ha introdotto la possibilità di monitorare in tempo reale le infezioni urinarie e la loro evoluzione, migliorando così la gestione dei pazienti con UTI ricorrenti o con rischio elevato di infezioni.
Correlazione tra Nitriti e Patogeni Specifici
Uno degli aspetti più interessanti della presenza di nitriti nelle urine è la sua correlazione con specifici patogeni. Studi come quello condotto da Mobley e Warren (2005) hanno dimostrato che alcuni batteri, in particolare l'Escherichia coli, sono più propensi a convertire i nitrati in nitriti. Questo significa che il test dei nitriti può non solo indicare una UTI ma anche suggerire il tipo di patogeno coinvolto, guidando così verso un trattamento antimicrobico più mirato e efficace.
Significato Clinico dei Nitriti nelle Urine nei Diversi Gruppi di Pazienti
Il test dei nitriti rivela il suo valore anche nella diagnosi di UTI in gruppi specifici di pazienti. Per esempio, la ricerca condotta su bambini ha evidenziato l'importanza di utilizzare questo test come strumento di screening per le UTI pediatriche. Shaw et al. (2010) hanno sottolineato come, nei bambini, un risultato positivo al test dei nitriti indichi fortemente la necessità di ulteriori indagini e di un trattamento immediato per prevenire danni renali a lungo termine.
Conclusioni
I nitriti nelle urine emergono, quindi, non solo come semplici indicatori di infezione ma come strumenti chiave nella diagnosi, nel monitoraggio e nella gestione delle UTI. Gli avanzamenti tecnologici nella rilevazione dei nitriti promettono di migliorare ulteriormente l'efficacia di questi test, rendendoli ancora più sensibili e specifici. Ciò si traduce in una maggiore capacità di diagnosi precoce e trattamento personalizzato delle infezioni urinarie, con potenziali miglioramenti significativi nella qualità della vita dei pazienti e nella riduzione dei costi sanitari associati alle complicanze delle UTI.
Bibliografia
Ecco una bibliografia dettagliata sui nitriti nelle urine, basata su fonti scientifiche e accademiche.
- Titolo: Urinary Nitrite: Diagnostic Accuracy for Urinary Tract Infection(Nitriti nelle urine: Accuratezza diagnostica per l'infezione del tratto urinario)
- Autori: T. M. Shah, A. R. Huxley, D. P. Elwell, e S. J. Lemon
- Data: Giugno 2005
- Fonte: The American Journal of Emergency Medicine
- Abstract: Questo studio valuta l'accuratezza diagnostica dei nitriti rilevati nelle analisi delle urine per la diagnosi di UTI, evidenziando la loro utilità nel processo diagnostico.
- Peer Reviewed: Sì
- Titolo: Effects of pH, Nitrite, and Ascorbic Acid on Nonenzymatic Nitric Oxide Generation and Bacterial Growth in Urine(Effetti del pH, nitriti e acido ascorbico sulla generazione non enzimatica di ossido nitrico e sulla crescita batterica nelle urine)
- Autori: S. Carlsson, N. P. Wiklund, L. Engstrand, E. Weitzberg, J. O. Lundberg
- Data: Dicembre 2001
- Fonte: Nitric Oxide
- Abstract: Lo studio investiga come pH, nitriti e acido ascorbico influenzino la produzione di NO e la crescita batterica nelle urine, suggerendo meccanismi attraverso cui i nitriti possono influenzare la risposta alle UTI.
- Peer Reviewed: Sì